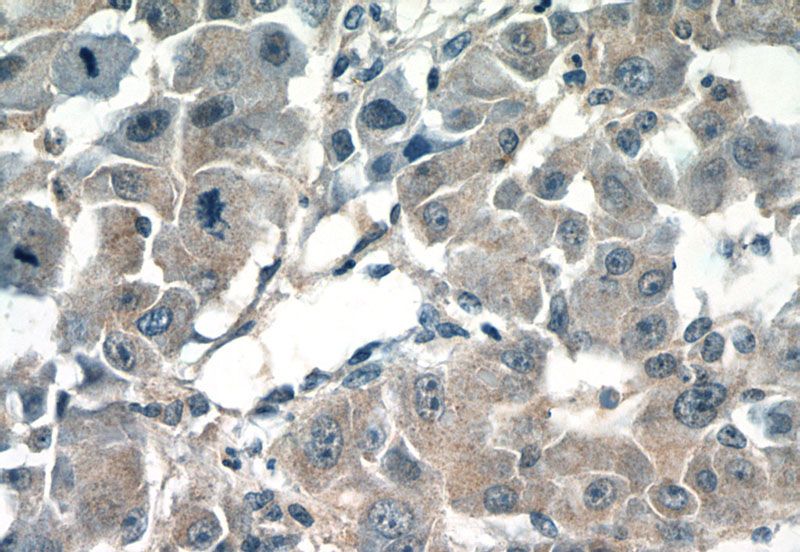
Immunohistochemistry of paraffin-embedded human liver cancer tissue slide using Catalog No:109506(CPEB1 Antibody) at dilution of 1:50 (under 40x lens)

-
Product Name
CPEB1 antibody
- Documents
-
Description
CPEB1 Rabbit Polyclonal antibody. Positive IHC detected in human liver cancer tissue, human breast cancer tissue, human colon cancer tissue. Positive WB detected in A375 cells, human heart tissue. Observed molecular weight by Western-blot: 54kd
-
Tested applications
ELISA, WB, IHC
-
Species reactivity
Human,Mouse,Rat; other species not tested.
-
Alternative names
CEBP antibody; CPE binding protein 1 antibody; CPE BP1 antibody; CPEB antibody; CPEB1 antibody; FLJ13203 antibody; h CEBP antibody; hCPEB 1 antibody
-
Isotype
Rabbit IgG
-
Preparation
This antibody was obtained by immunization of CPEB1 recombinant protein (Accession Number: NM_001387073). Purification method: Antigen affinity purified.
-
Clonality
Polyclonal
-
Formulation
PBS with 0.02% sodium azide and 50% glycerol pH 7.3.
-
Storage instructions
Store at -20℃. DO NOT ALIQUOT
-
Applications
Recommended Dilution:
WB: 1:500-1:5000
IHC: 1:20-1:200
-
Validations

A375 cells were subjected to SDS PAGE followed by western blot with Catalog No:109506(CPEB1 antibody) at dilution of 1:1000

Immunohistochemistry of paraffin-embedded human breast cancer tissue slide using Catalog No:109506(CPEB1 Antibody) at dilution of 1:50 (under 40x lens)
Immunohistochemistry of paraffin-embedded human liver cancer tissue slide using Catalog No:109506(CPEB1 Antibody) at dilution of 1:50 (under 40x lens)
-
Background
CPEB1, also named as CEBP, CPEB and CPE-BP1, contains two RRM (RNA recognition motif) domains and belongs to the RRM CPEB family. It is a sequence-specific RNA-binding protein that regulates mRNA cytoplasmic polyadenylation and translation initiation during oocyte maturation, early development and at postsynapse sites of neurons. CPEB1 regulated translation is a key process involved in insulin signaling. This is a rabbit polyclonal antibody raised against residues near the C terminus of human CPEB1. This antibody may recognize several bands, but only ~56kDa band is the right one, other(40~50kDa) is un-specific bands.
-
References
- Bava FA, Eliscovich C, Ferreira PG. CPEB1 coordinates alternative 3'-UTR formation with translational regulation. Nature. 495(7439):121-5. 2013.
- Grudzien-Nogalska E, Reed BC, Rhoads RE. CPEB1 promotes differentiation and suppresses EMT in mammary epithelial cells. Journal of cell science. 127(Pt 10):2326-38. 2014.
- Giangarrà V, Igea A, Castellazzi CL, Bava FA, Mendez R. Global Analysis of CPEBs Reveals Sequential and Non-Redundant Functions in Mitotic Cell Cycle. PloS one. 10(9):e0138794. 2015.
- Ochi H, Aoto S, Tachibana K, Hara M, Chiba K. Block of CDK1-dependent polyadenosine elongation of Cyclin B mRNA in metaphase-i-arrested starfish oocytes is released by intracellular pH elevation upon spawning. Molecular reproduction and development. 83(1):79-87. 2016.
Related Products / Services
Please note: All products are "FOR RESEARCH USE ONLY AND ARE NOT INTENDED FOR DIAGNOSTIC OR THERAPEUTIC USE"
